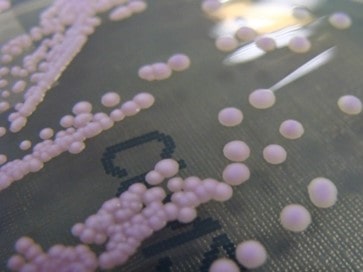

Candida tropicalis shop
Candida tropicalis Wikipedia shop, Candida tropicalis An Overview shop, Candida tropicalis An Overview shop, Candida albicans SC 5314 Candida tropicalis YJM 57 Lodderomyces shop, Candida tropicalis Wikipedia shop, Candida tropicalis Wikipedia shop, Candida tropicalis Microchem Laboratory shop, Isolation and Identification of Candida tropicalis as a Cause of shop, Frontiers An Update on Candida tropicalis Based on Basic and shop, A Candida tropicalis bluish purple colonies. B The appearance shop, Candida Tropicalis J st Mikroskopiska Svampar Som Orsakar shop, Candida Tropicalis an overview ScienceDirect Topics shop, Candida Tropicalis Yeasts 3D Illustration Stock Illustration shop, Candida tropicalis microculture on the modified agar Nickerson shop, NCYC 4 Candida tropicalis National Collection of Yeast Cultures shop, Candida Tropicalis Yeasts 6 by Kateryna Kon science Photo Library shop, mICROBIO on X shop, Significance of hyphae formation in virulence of Candida shop, Candida albicans Candida krusei and Candida tropicalis colony morphology on Candida Chromagar shop, Stock illustrationen Candida tropicalis yeasts Adobe Stock shop, Candida Tropicalis Yeasts Illustration 1 by Kateryna Kon shop, diArk species list Candida tropicalis Y6604 shop, Microbe Notes Candida tropicalis. Image Source shop, IJMS Free Full Text Raman Spectroscopy of Oral Candida Species shop, Frontiers Evaluation of Virulence Factors In vitro Resistance shop, Candida Tropicalis Yeasts Hand Drawn Illustration Stock shop, Candida Tropicalis Yeasts Illustration iPhone X Case shop, Candida Tropicalis Yeasts Illustration Greeting Card shop, Candida tropicalis Infection Modulates the Gut Microbiome and shop, Candida tropicalis on CHROMagar Download Scientific Diagram shop, Candida tropicalis yeasts illustration Stock Image F036 0528 shop, Genetically similar fungi cause severe infections in different shop, Candida tropicalis yeasts stock illustration. Illustration of shop, Candida Tropicalis Yeasts Microscopic Fungi Cause Infections shop, Candida tropicalis Agentes biol gicos Hongos shop.
-
Next Day Delivery by DPD
Find out more
Order by 9pm (excludes Public holidays)
$11.99
-
Express Delivery - 48 Hours
Find out more
Order by 9pm (excludes Public holidays)
$9.99
-
Standard Delivery $6.99 Find out more
Delivered within 3 - 7 days (excludes Public holidays).
-
Store Delivery $6.99 Find out more
Delivered to your chosen store within 3-7 days
Spend over $400 (excluding delivery charge) to get a $20 voucher to spend in-store -
International Delivery Find out more
International Delivery is available for this product. The cost and delivery time depend on the country.
You can now return your online order in a few easy steps. Select your preferred tracked returns service. We have print at home, paperless and collection options available.
You have 28 days to return your order from the date it’s delivered. Exclusions apply.
View our full Returns and Exchanges information.